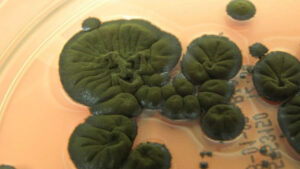

თიბისის მხარდაჭერითა და საქართველოს ხელოვნური ინტელექტის ასოციაციის (GAIA) ინიციატივით საქართველოს ეროვნული AI ოლიმპიადის პირველი ტური ჩატარდა. სწორედ ეროვნული ოლიმპიადის გამარჯვებულებისგან დაკომპლექტდება მოსწავლეთა ეროვნული ნაკრები, რომელიც 2025 წელს საქართველოს პირველად წარადგენს ხელოვნური ინტელექტის მსოფლიო ოლიმპიადაზე (IOAI).
ეროვნული AI ოლიმპიადის პირველი ტური 27 აპრილს გაიმართა და მასში მონაწილეობა IX-XII კლასის 100-მდე მოსწავლემ მიიღო მთელი საქართველოდან, მეორე ტურში კი საუკეთესო შედეგის 30 მონაწილე გადავა.
მეორე, ფინალური ტურის საბოლოო მონაცემების მიხედვით კი (რომელიც მაისის ბოლოს ჩატარდება), ეროვნული ნაკრები დაკომპლექტდება. 4 წევრიანი ნაკრები 2-9 აგვისტოს პეკინში გამართულ ხელოვნური ინტელექტის საერთაშორისო ოლიმპიადაზე საქართველოს სახელით იასპარეზებს.
ხელოვნური ინტელექტის საერთაშორისო ოლიმპიადა (IOAI) საერთაშორისო საგანმანათლებლო კონკურსია, რომელიც 2024 წლიდან ტარდება და უკვე აერთიანებს ხელოვნური ინტელექტითა და მონაცემთა მეცნიერებით დაინტერესებულ სკოლის მოსწავლეებს მსოფლიოს 60-ზე მეტი ქვეყნიდან. IOAI უკვე გახდა მოსწავლეთა მსოფლიო ოლიმპიადების სისტემის ერთ-ერთი ყველაზე პრესტიჟული ნაწილი.
ხელოვნური ინტელექტის ეროვნული ოლიმპიადა მნიშვნელოვანი ინიციატივაა, როგორც საქართველოს AI და ტექნოლოგიური ეკოსისტემის განვითარებისთვის, ისე ქვეყნის საერთაშორისო ტექნოლოგიურ საზოგადოებაში ინტეგრირებისთვის. ოლიმპიადაში მონაწილეობა ახალგაზრდების AI მიმართულებით პროფესიულ ზრდას, ცოდნის გაზიარებასა და პრაქტიკული უნარების გაღრმავებას უწყობს ხელს. ამასთან, მონაწილეებს აძლევს შანსს, დაამყარონ ახალი კავშირები დარგის წამყვან პროფესიონალებთან საოლიმპიადო კურსის ფარგლებში, რომელიც ოლიმპიადისთვის მოსამზადებლად GAIA-მ თიბისის მხარდაჭერით შეიქმნა. ოლიმპიადის მხარდამჭერია საქართველოს ინოვაციების და ტექნოლოგიების სააგენტო.
თიბისი, როგორც ახალი თაობის განათლების ხელშემწყობი წამყვანი კომპანია, საოლიმპიადო კურსის, ეროვნული ოლიმპიადისა და IOAI-ზე საქართველოს ეროვნული ნაკრების მთავარი მხარდამჭერია. GAIA-სთან პარტნიორობის ფარგლებში, თიბისის მონაცემთა მეცნიერების გუნდის პროფესიონალები კურსის მენტორები არიან და მოსწავლეებს აქტიურად უჭერენ მხარს ოლიმპიადისთვის მომზადებაში.